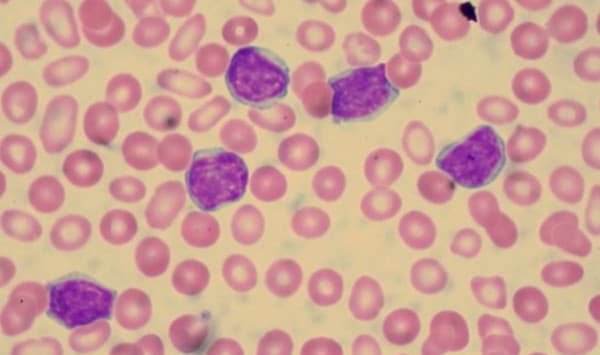

Namanya memberikan kesan bahwa LLK merupakan suatu jenis leukemia. Pengobatan leukemia kronik.

Bacaan Anda Leukemia Limfositik Kronis
Biasanya penyakit ini sering terjadi selama atau setelah usia pertengahan dan jarang terjadi pada anak-anak.

Leukemia limfositik kronis. Leukemia limfositik kronis LLK adalah jenis kanker pada sumsum tulang dan sel darah. Leukemia kronis diklasifikasikan menurut jenis sel darah putih yang terkena kanker. Pengertian leukemia limfositik kronis.
Leukemia limfositik kronis CLL adalah salah satu kanker darah di mana sumsum tulang memproduksi limfosit terlalu banyak. 1 Leukemia Limfositik Kronik LLK Leukemia Limfositik Kronik LLK adalah suatu keganasan yang ditandai proliferasi klonal limfosit B neoplastik. Pelajari tentang gejala faktor risiko dan pengobatan.
Leukemia limfositik kronis alias CLL biasanya baru terdeteksi pada stadium lanjut karena penderita cenderung tidak merasakan gejala-gejalanya dalam jangka waktu lama. Kata kronis pada leukemia limfositik ini menandakan bahwa penyakit berkembang atau memburuk secara perlahan. Penyakit ini jarang ditemukan pada orang berusia di bawah 40 tahun.
Tanda pada LLK meliputi limfositosis. Leukemia akut tumbuh dengan cepat bila tidak diobati sementara leukemia kronis membutuhkan waktu yang lebih lama untuk berkembang. Dengan kata lain pasien tidak merasakan gejala diawal kondisi muncul.
Pada tipe kanker darah ini penyakit berkembang secara lambat. Acute myeloblastic leukemia AML atau leukemia mieloblastik akut terjadi ketika sumsum tulang terlalu banyak memproduksi sel. Jika leukemia limfositik kronis masih dalam tahap awal dokter mungkin memutuskan bahwa ia belum perlu mengobatinya ia mungkin merekomendasikan observasi dan pemantauan ketat terhadap kondisi pasien dengan tes darah rutin yang dilakukan setiap 3 bulan dan setelah 12 bulan tim medis menilai kembali rencana perawatan.
LLK adalah salah satu jenis leukemia yang paling umum pada orang dewasa. Leukemia adalah kanker sel darah putih. Cari tahu bagaimana CLL didiagnosis dan dipentaskan.
Leukemia bersifat akut atau kronis bergantung kepada sel darah mana yang terlibat dan seberapa cepat pertumbuhannya. Leukemia Limfositik Kronis Pada leukemia jenis ini adalah kondisi dimana terdapat terlalu banyak limfosit sejenis sel darah putih. Leukemia limfositik kronis juga disebut LLK adalah penyakit darah dan sumsum tulang yang biasanya memburuk secara perlahan.
Leukemia jenis ini paling awam terjadi pada orang dewasa yang berusia di atas 55 tahun meskipun orang-orang berusia lebih muda juga dapat mengidapnya. Leukemia limfositik kronis LLK adalah jenis kanker darah yang pertumbuhannya lambat yang mempengaruhi limfosit yaitu suatu jenis sel darah putih. Chronic lymphocytic leukemia CLL atau leukemia limfositik kronis terjadi ketika sumsum tulang terlalu banyak memproduksi limfosit yang tidak normal dan secara perlahan menyebabkan kanker.
Leukemia jenis ini adalah jenis leukemia kedua yang paling umum pada orang dewasa. Leukemia limfositik kronis CLL adalah suatu bentuk kanker yang mempengaruhi limfosit Anda sejenis sel darah putih. Ada dua tipe utama.
Dapatkan juga informasi tentang tingkat kelangsungan hidup komplikasi pengobatan dan banyak lagi. Leukemia limfositik kronik berkembang dengan lambat sehingga banyak penderita yang tidak me ndapatkan pen anganan selama bertahun-tahun sampai jumlah limfosit sangat banyak kelenjar getah bening membesar atau terjadi penurunan jumlah eritrosit atau trombosit. Leukemia limfositik kronis CLL adalah kanker darah akibat gangguan pada sumsum tulang.
Leukemia Limfositik Kronik LLK adalah suatu keganasan hematologik yang ditandai oleh proliferasi klonal dan penumpukan limfosit B neoplastik dalam darah. Penyebab LLK belum diketahui ada kemungkinan yang berperan adalah abnormalitas kromosom onkogen dan retrovirus RNA tumour virus. Kanker jenis ini ditandai dengan produksi sel darah putih limfosit berlebih sehingga terjadi penumpukan limfosit pada darah sumsum tulang belakang limfonodi limpa hati dan organ organ lain.
Apa itu leukemia limfositik kronis. Leukemia kronis cenderung berkembang perlahan selama bertahun-tahun. Penderita umunya berusia lanjut yaitu rata-rata 70 tahun.
Halaman-halaman ini berfokus pada leukemia limfositik kronis. Ada 4 subtipe leukemia yang ditemukan yaitu leukemia limfositik akut leukemia mieloid akut leukemia limfositik kronik dan leukemia mieloid kronik. Sel darah putih normal berkontribusi pada pertahanan tubuh melawan infeksi.
Patofisiologi leukemia limfositik kronis Sekitar 98 kasus adalah transformasi sel CD4 ganas dengan akumulasi awal limfosit di sumsum tulang dan selanjutnya menyebar ke kelenjar getah bening jaringan limfoid lainnya yang akhirnya menyebabkan splenomegali dan hepatomegali. Leukemia limfositik kronis adalah jenis kanker di mana sumsum tulang membuat terlalu banyak limfosit sejenis sel darah putih. CLL adalah salah satu jenis leukemia yang paling umum terjadi pada orang dewasa dan sering terjadi selama atau setelah usia pertengahan.
Jumlah pengidap LLK hanya 10 persen dari semua jenis leukemia dan umumnya diidap oleh lansia. Leukemia limfositik kronis adalah jenis leukemia yang paling sering terjadi pada orang dewasa. Leukemia limfositik kronis.
Leukemia kronik merupakan suatu penyakit yang ditandai dengan proliferasi neoplastik dari salah satu sel yang dapat terjadi karena keganasan hematologi. Suatu leukemia dikatakan akut atau kronik adalah tergantung pada sebagian besar sel-sel abnormal yang dijumpai. Namun ini adalah pengertian yang keliru sesungguhnya LLK dikategorikan sebagai limfoma yang umumnya memiliki progonosis yang.
Usia rerata pasien saat didiagnosis berusia 65. Apakah Yang Dimaksud Dengan Leukemia Limfositik Kronis LLK.

Gejala Leukemia Limfositik Kronis Penyebab Biaya Berobat Dokter Smarter Health
Leukemia Limfositik Kronis Llk Penyebab Dan Pengobatannya

Tanyadok Com Serba Serbi Leukemia

Waspada 5 Gejala Leukemia Ini Sering Kali Diabaikan Salah Satunya Memar Di Tubuh Yang Tiba Tiba Muncul Semua Halaman Intisari

Leukemia Akut Tanda Dan Gejala Penyebab Cara Mengobati Cara Mencegah

Leukemia Patofisiologi Diagnosis Penatalaksanaan Alomedika

Pemeriksaan Darah Rutin Pada Leukemia Info Laboratorium Medik

Kanker Leukemia Penyakit Kanker Pada Sel Darah Deherba Com

Bacaan Anda Leukemia Limfositik Kronis

Kenali Klasifikasi Dan Tipe Kanker Darah Penyakit Yang Diidap Ani Yudhoyono Tribun Palu

Klasifikasi Leukemia Mieloblastik Akut Aml Menurut Fab Patologi Klinik
Http Repository Unimus Ac Id 1284 3 Bab 20ii Pdf

Pin Di Daftar Informasi Penyakit Sehatq Com

Kanker Leukemia Penyakit Kanker Pada Sel Darah Deherba Com

Kanker Darah Jenis Penyebab Gejala Dan Pengobatan Tokopedia Blog

Leukemia Limfositik Kronis Tanda Dan Gejala Penyebab Cara Mengobati Cara Mencegah

Gejala Leukemia Mieloid Kronis Penyebab Biaya Berobat Dokter Smarter Health
Http Repository Unimus Ac Id 1284 3 Bab 20ii Pdf
YOU MAY LIKE :